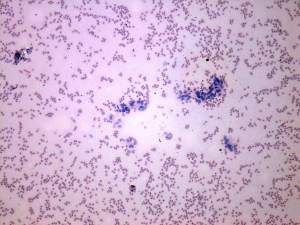

Follicular carcinoma - Case 9. |
|
Clinical data: a 36-year-old woman was sent for an evaluation of a thyroid nodule discovered incidentally.
Functional state: euthyroidism (TSH-level 1.41 mIU/L).
Palpation: no abnormality.
Ultrasonography: a hypoechogenic nodule can be seen in the right lobe without a halo sign, but with perinodular blood flow.
Cytological picture: there was no colloid on the smear. There were thyrocytes located in atypical microfollicles with nuclear crowding. Follicular cells were enlarged but did not display pleomorphism.
Cytological diagnosis: follicular tumor with higher than the average risk for carcinoma.
Histopatholog: follicular cancer - minimally invasive type.